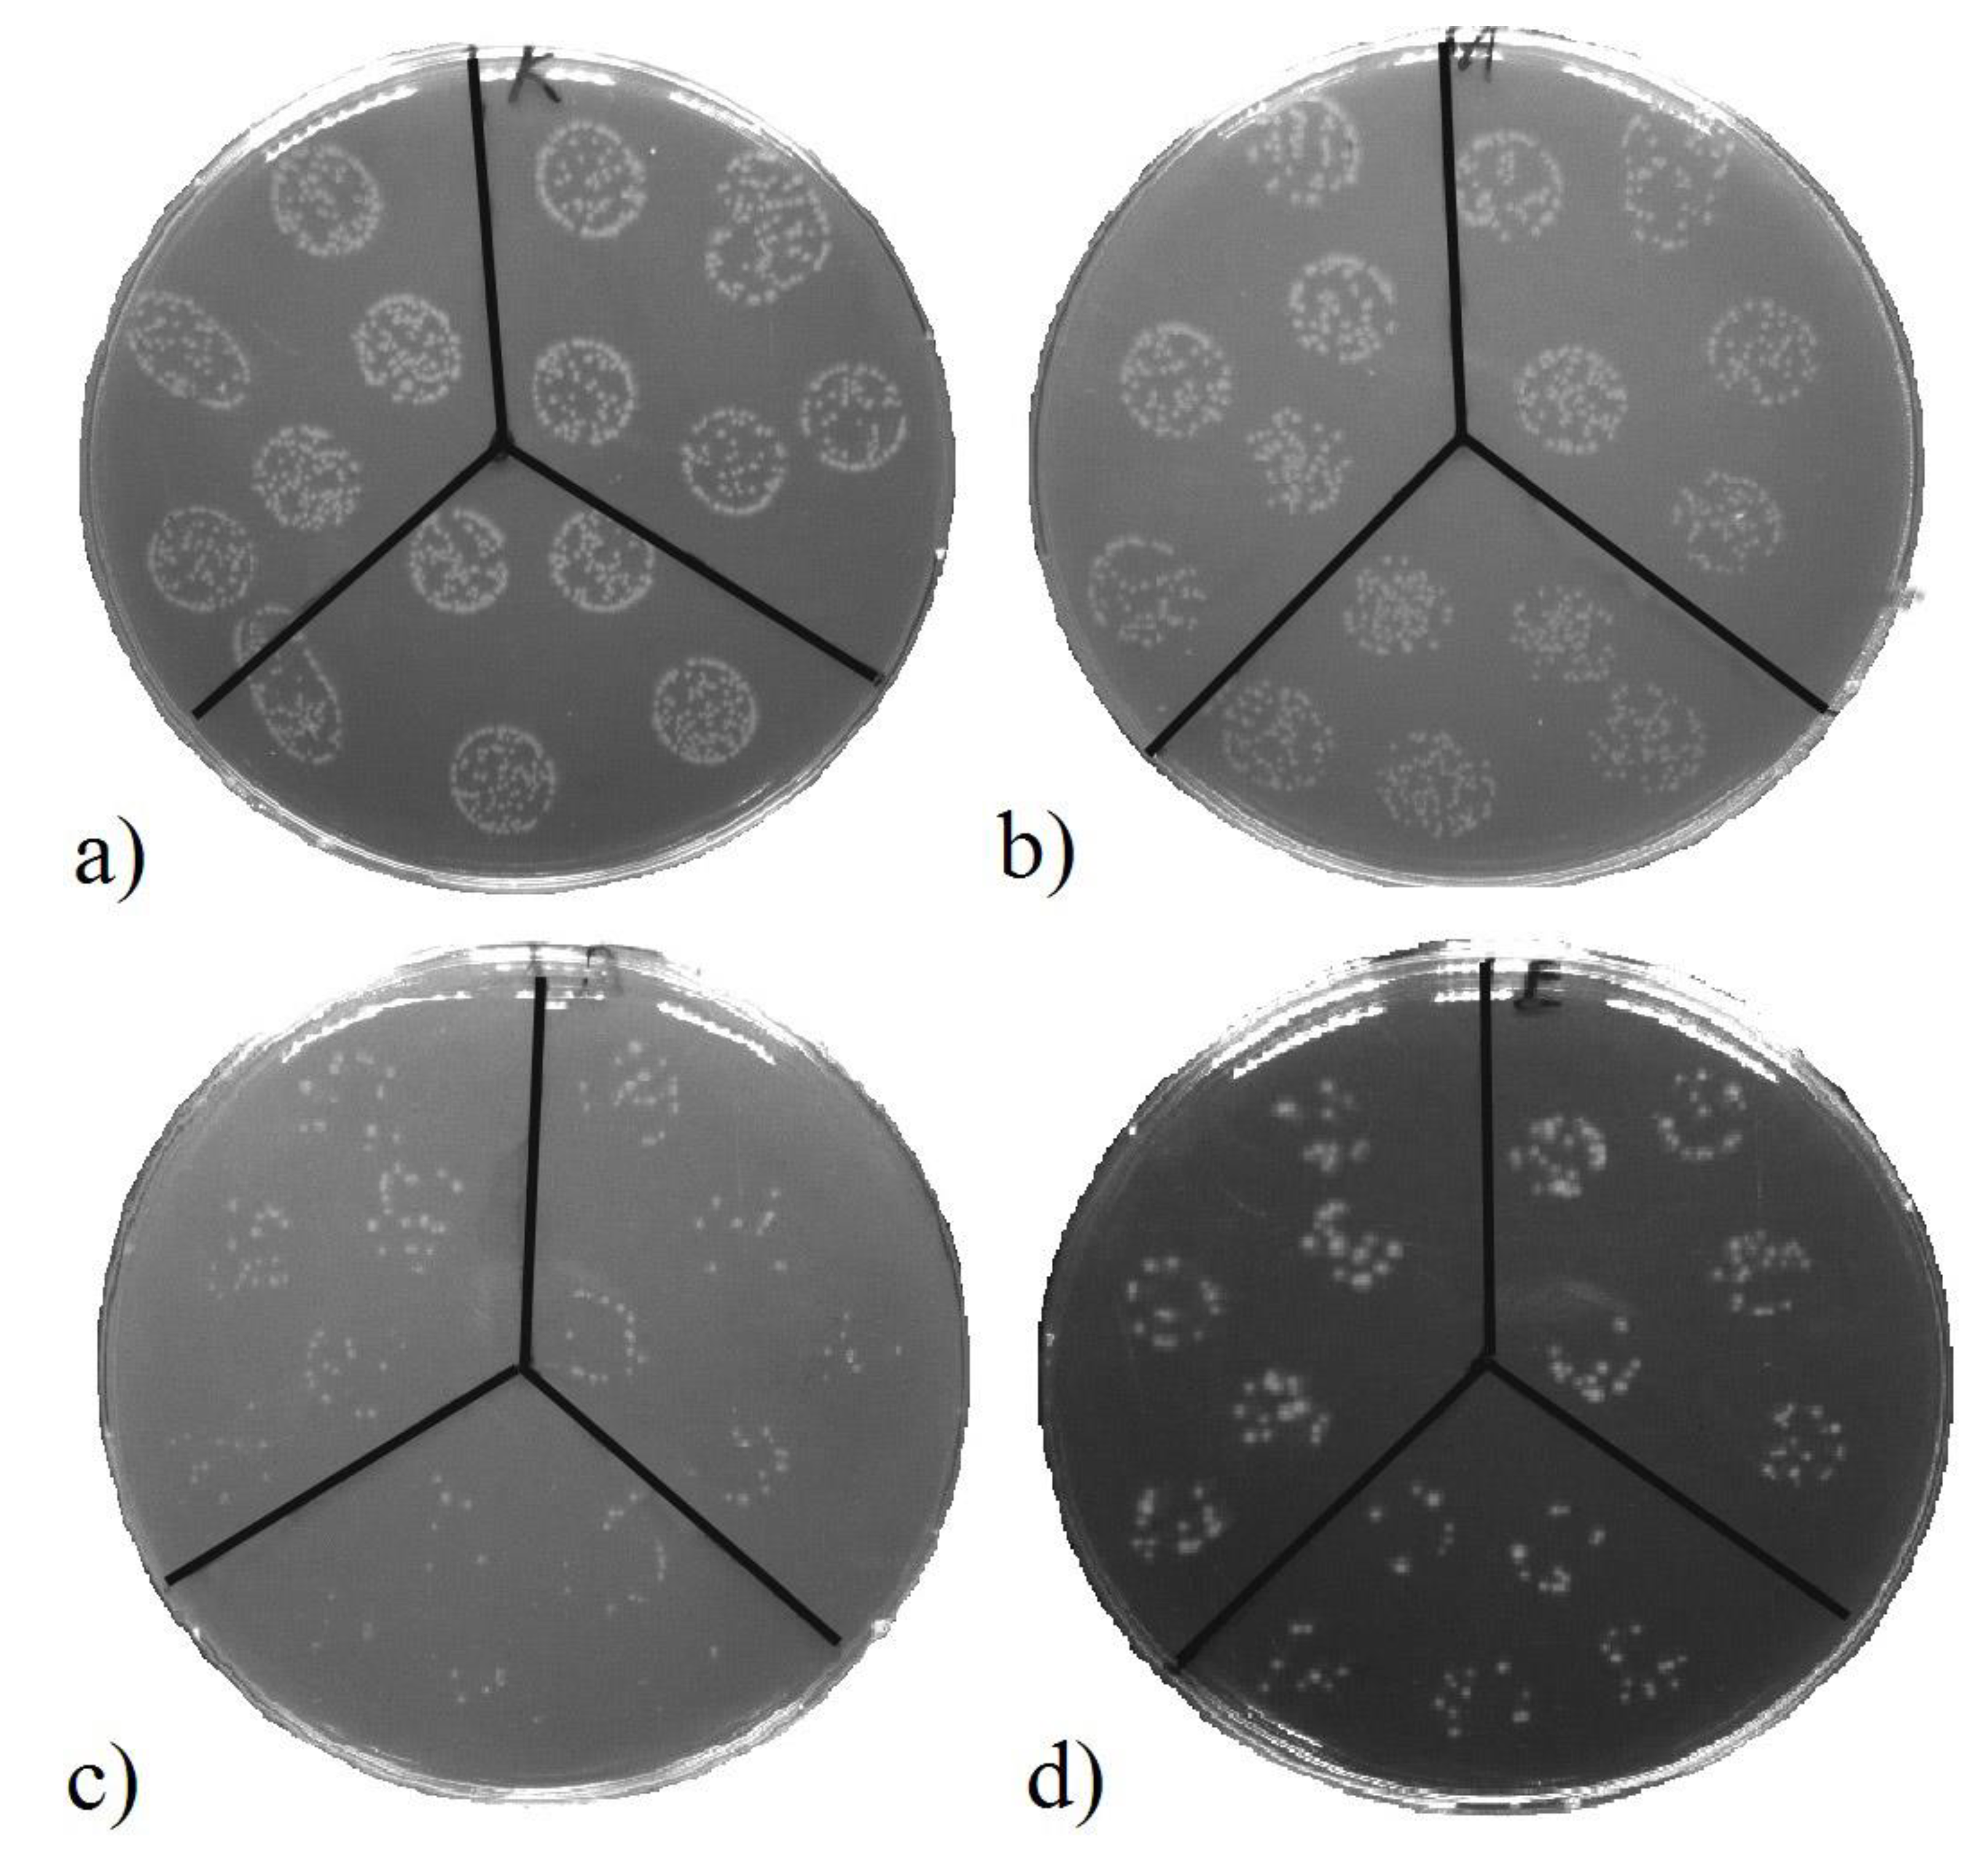
Pharmaceutics 13 00826 g013 Pharmaceutics 13 00826 g013

Biopolymer Composites with Ti/Au Nanostructures and Their Antibacterial Properties
Abstract
1. Introduction
2. Materials and Methods
2.1. Materials and Modification
2.2. Analytical Methods
2.3. Antibacterial Activity
3. Results
3.1. Sample Surface Morphology by LCM Analysis
3.2. Sample Surface Morphology by AFM Analysis
3.3. Surface Chemistry
3.4. Sample Wettability and Its Zeta-Potential
3.5. Antibacterial Activity of the Samples
4. Conclusions
Author Contributions
Funding
Institutional Review Board Statement
Informed Consent Statement
Data Availability Statement
Conflicts of Interest
References
- Zheng, J.; Teng, L. Bifurcation instability of substrate-supported metal films under biaxial in-plane tension. J. Mech. Phys. Solids 2019, 126, 52–75. [Google Scholar] [CrossRef]
- Yu, S.J.; Du, Y.P.; Sun, Y.D.; Ye, Q.L.; Zhou, H. Wrinkling patterns in metal films sputter deposited on viscoelastic substrates. Thin Solid Films 2017, 638, 230–235. [Google Scholar] [CrossRef]
- Li, K.; Wang, J.; Shao, B.; Xiao, J.; Zhou, H.; Yu, S. Wrinkling patterns of tantalum films on modulus-gradient compliant substrates. Thin Solid Films 2018, 654, 100–106. [Google Scholar] [CrossRef]
- Yu, S.; Sun, Y.; Li, S.; Ni, Y. Harnessing fold-to-wrinkle transition and hierarchical wrinkling on soft material surfaces by regulating substrate stiffness and sputtering flux. Soft Matter 2018, 14, 6745–6755. [Google Scholar] [CrossRef]
- Li, S.J.; Wu, K.; Yuan, H.Z.; Zhang, J.Y.; Liu, G.; Sun, J. Formation of wrinkled patterns in metal films deposited on elastic substrates: Tunability and wettability. Surf. Coat. Technol. 2019, 362, 35–43. [Google Scholar] [CrossRef]
- Zhao, Y.; Huang, W.M.; Fu, Y.Q. Formation of micro/nano-scale wrinkling patterns atop shape memory polymers. J. Micromechanics Microeng. 2011, 21, 067007. [Google Scholar] [CrossRef]
- Juřík, P.; Slepička, P.; Mistrík, J.; Janíček, P.; Rimpelová, S.; Kolská, Z.; Švorčík, V. Oriented gold ripple-like structures on poly-L-lactic acid. Appl. Surf. Sci. 2014, 321, 503–510. [Google Scholar] [CrossRef]
- Juřík, P.; Slepička, P.; Nagyová, M.; Švorčík, V. Wrinkle pattern on PLLA induced by stress of polymer-metal bilayer. Surf. Coat. Technol. 2017, 311, 344–350. [Google Scholar] [CrossRef]
- Krajcar, R.; Siegel, J.; Slepička, P.; Fitl, P.; Švorčík, V. Silver nanowires prepared on PET structured by laser irradiation. Mater. Lett. 2014, 117, 184–187. [Google Scholar] [CrossRef]
- Slepička, P.; Chaloupka, A.; Sajdl, P.; Heitz, J.; Hnatowicz, V.; Švorčík, V. Angle dependent laser nanopatterning of poly(ethylene terephthalate) surfaces. Appl. Surf. Sci. 2011, 257, 6021–6025. [Google Scholar] [CrossRef]
- Michaljaničová, I.; Slepička, P.; Rimpelová, S.; Slepičková Kasálková, N.; Švorčík, V. Regular pattern formation on surface of aromatic polymers and its cytocompatibility. Appl. Surf. Sci. 2016, 370, 131–141. [Google Scholar] [CrossRef]
- Barb, R.A.; Hrelescu, C.; Dong, L.; Heitz, J.; Siegel, J.; Slepička, P.; Vosmanská, V.; Švorčík, V.; Magnus, B.; Marksteiner, R.; et al. Laser-induced periodic surface structures on polymers for formation of gold nanowires and activation of human cells. Appl. Phys. A 2014, 117, 295–300. [Google Scholar] [CrossRef]
- Neděla, O.; Slepička, P.; Malý, J.; Štofík, M.; Švorčík, V. Laser-induced nanostructures on a polymer irradiated through a contact mask. Appl. Surf. Sci. 2014, 321, 173–178. [Google Scholar] [CrossRef]
- Slepička, P.; Neznalová, K.; Fajstavr, D.; Švorčík, V. Nanostructuring of honeycomb-like polystyrene with excimer laser. Prog. Organic Coat. 2020, 145, 105670. [Google Scholar] [CrossRef]
- Yu, S.; Zhang, X.; Xiao, X.; Zhou, H.; Chen, M. Wrinkled stripes localized by cracks in metal films deposited on soft substrates. Soft Matter 2015, 11, 2203–2212. [Google Scholar] [CrossRef]
- Goel, P.; Kumar, S.; Sarkar, J.; Singh, J.P. Mechanical strain induced tunable anisotropic wetting on buckled PDMS silver nanorods arrays. ACS Appl. Mater. Interfaces 2015, 7, 8419–8426. [Google Scholar] [CrossRef]
- Mei, Y.; Kiravittaya, S.; Harazim, S.; Schmidt, O.G. Principles and applications of micro and nanoscale wrinkles. Mater. Sci. Eng. R 2010, 70, 209–224. [Google Scholar] [CrossRef]
- Ko, P.L.; Chang, F.L.; Li, C.H.; Chen, J.Z.; Cheng, I.C.; Tung, Y.C.; Lin, P.C. Dynamically programmable surface micro-wrinkles on PDMS-SMA composite. Smart Mater Struct. 2014, 23, 115007. [Google Scholar] [CrossRef]
- Lee, T.D.; Ebong, A.U. A review of thin film solar cell technologies and challenges. Renew. Sust. Energy Rev. 2017, 70, 1286–1297. [Google Scholar] [CrossRef]
- Aberle, A.G. Thin-film solar cells. Thin Solid Films 2009, 517, 4706–4710. [Google Scholar] [CrossRef]
- Oh, M.K.; De, R.; Yim, S.Y. Highly sensitive VOC gas sensor employing deep cooling of SERS film. J Raman Spectrosc. 2018, 49, 800–809. [Google Scholar] [CrossRef]
- Oh, M.-K.; Shin, Y.-S.; Lee, C.-L.; De, R.; Kang, H.; Yu, N.E.; Kim, B.H.; Kim, J.H.; Yang, J.-K. Morphological and SERS Properties of Silver Nanorod Array Films Fabricated by Oblique Thermal Evaporation at Various Substrate Temperatures. Nanoscale Res. Lett. 2015, 10, 259. [Google Scholar] [CrossRef] [PubMed]
- De, R.; Shin, Y.S.; Lee, C.L.; Oh, M.K. Long-Standing Stability of Silver Nanorod Array Substrates Functionalized Using a Series of Thiols for a SERS-Based Sensing Application. Appl. Spectroscopy. 2016, 70, 1137–1149. [Google Scholar] [CrossRef]
- Sertel, B.C.; Sonmez, N.A.; Kaya, M.D.; Ozcelik, S. Development of MgO:TiO2 thin films for gas sensor applications. Ceramics Int. 2019, 45, 2917–2921. [Google Scholar] [CrossRef]
- Huang, J.J.; Lin, C.C.; Wuu, D.S. Antireflection and passivation property of titanium oxide thin film on silicon nanowire by liquid phase deposition. Surf. Coat. Technol. 2017, 320, 252–258. [Google Scholar] [CrossRef]
- Tec-Yam, S.; Rojas, J.; Rejón, V.; Oliva, A.I. High quality antireflective ZnS thin films prepared by chemical bath deposition. Mater. Chem. Phys. 2012, 136, 386–393. [Google Scholar] [CrossRef]
- Ulaeto, S.B.; Rajan, R.; Pancrecious, J.K.; Rajan, T.P.D.; Pai, B.C. Developments in smart anticorrosive coatings with multifunctional characteristics. Prog. Organic Coat. 2017, 111, 294–314. [Google Scholar] [CrossRef]
- Abreu, C.S.; Matos, J.; Cavaleiro, A.; Alves, E.; Barradas, N.P.; Vaz, F.; Torrell, M.; Gomes, J.R. Tribological characterization of TiO2/Au decorative thin films obtained by PVD magnetron sputtering technology. Wear 2015, 330–331, 419–428. [Google Scholar] [CrossRef]
- Slepička, P.; Slepičková Kasálková, N.; Siegel, J.; Kolská, Z.; Švorčík, V. Methods of gold and silver nanoparticles preparation. Materials 2019, 13, 1. [Google Scholar] [CrossRef]
- Romanenko, O.; Slepička, P.; Malinský, P.; Cutroneo, M.; Havránek, V.; Stammers, J.; Švorčík, V.; Macková, A. The influence of Au-nanoparticles presence in PDMS on microstructures creation by ion beam lithography. Surf. Interface Anal. 2020, 52, 1040–1044. [Google Scholar] [CrossRef]
- Slepičková Kasálková, N.; Slepička, P.; Ivanovská, B.; Trávníčková, M.; Malinský, P.; Macková, A.; Bačáková, L.; Švorčík, V. Plasma-activated polyvinyl alcohol foils for cell growth. Coatings 2020, 10, 1083. [Google Scholar] [CrossRef]
- Juřík, P.; Slepička, P.; Kolská, Z.; Slepičková Kasálková, N.; Švorčík, V. Nanostrukturování polymerních substrátů pomocí indukovaného vrásnění. Chem. Listy 2020, 114, 804–814. [Google Scholar]
- Lišková, J.; Slepičková Kasálková, N.; Slepička, P.; Švorčík, V.; Bačáková, L. Heat-treated carbon coatings on poly (L-lactide) foils for tissue engineering. Mater. Sci. Eng. C 2019, 100, 117–128. [Google Scholar] [CrossRef] [PubMed]
- Slepicka, P.; Siegel, J.; Lyutakov, O.; Slepickova Kasalkova, N.; Kolska, Z.; Bacakova, L.; Svorcik, V. Polymer nanostructures for bioapplications induced by laser treatment. Biotechnol. Adv. 2018, 36, 839–855. [Google Scholar] [CrossRef]
- Fajstavr, D.; Neznalová, K.; Švorčík, V.; Slepička, P. LIPSS structures induced on graphene-polystyrene composite. Materials 2019, 12, 3460. [Google Scholar] [CrossRef]
- Chen, L.; Chen, N.; Li, Y.; Li, W.; Zhou, X.; Wang, Z.; Zhao, Y.; Bu, Y. Metal-dielectric pure red to gold special effect coatings for security and decorative applications. Surf. Coat. Technol. 2019, 363, 18–24. [Google Scholar] [CrossRef]
- Balázsi, K.; Vandrovcová, M.; Bačáková, L.; Balázsi, C. Structural and biocompatible characterization of TiC/a:C nanocomposite thin films. Mater. Sci. Eng. C 2013, 33, 1671–1675. [Google Scholar] [CrossRef]
- Achache, S.; Alhussein, A.; Lamri, S.; François, M.; Sanchette, F.; Pulgarin, C.; Kiwi, J.; Rtimi, S. Sputtered Gum metal thin films showing bacterial inactivtion and biocompatibility. Colloids Surf. B 2016, 146, 687–691. [Google Scholar] [CrossRef] [PubMed]
- Hsieh, J.H.; Lai, Y.H.; Lin, Y.C.; Liao, S.J.; Li, C.; Chang, Y.; Hu, C. Structure analysis, mechanical property, and biocompatibility of TaOxNy thin films. Surf. Coat. Technol. 2016, 303, 54–60. [Google Scholar] [CrossRef]
- Chu, J.P.; Jang, J.S.C.; Huang, J.C.; Chou, H.S.; Yang, Y.; Ye, J.C.; Rullyani, C. Thin film metallic glasses: Unique properties and potential applications. Thin Solid Films 2012, 520, 5097–5122. [Google Scholar] [CrossRef]
- Lou, B.S.; Yang, Y.C.; Lee, J.W.; Chen, L.T. Biocompatibility and mechanical property evaluation of Zr-Ti-Fe based ternary thin film metallic glasses. Surf. Coat. Technol. 2017, 320, 512–519. [Google Scholar] [CrossRef]
- Karki, S.; Kim, H.; Na, S.J.; Shin, D.; Jo, K.; Lee, J. Thin films as an emerging platform for drug delivery. Asian J. Pharm. Sci. 2016, 11, 559–574. [Google Scholar] [CrossRef]

| Ti Base Layer | Au Base Layer | ||
|---|---|---|---|
| Ti [nm] | Au [nm] | Au [nm] | Ti [nm] |
| 2 | 48 | 2 | 28 |
| 5 | 45 | 5 | 25 |
| 10 | 40 | 10 | 20 |
| 25 | 25 | 25 | 5 |
| Sample | Amplitude [nm] | Width [μm] |
|---|---|---|
| Ti 5 nm, Au 45 nm | 18.7 ± 2.8 | 0.25 ± 0.03 |
| Ti 10 nm, Au 40 nm | 27.4 ± 4.1 | 0.32 ± 0.06 |
| Au 10 nm, Ti 20 nm | 59.8 ± 9.5 | 0.45 ± 0.03 |
| Sample | C | O | Ti | Au | ||||
|---|---|---|---|---|---|---|---|---|
| Unheated | Wt % | At % | Wt % | At % | Wt % | At % | Wt % | At % |
| Au 5 nm, Ti 25 nm | 82.5 | 90.5 | 9.4 | 7.8 | 6.0 | 1.7 | 2.0 | 0.1 |
| Au 10 nm, Ti 20 nm | 72.5 | 80.3 | 22.7 | 18.9 | 2.3 | 0.7 | 2.5 | 0.2 |
| Au 25 nm, Ti 5 nm | 70.6 | 83.9 | 16.6 | 14.8 | 1.6 | 0.5 | 11.2 | 0.8 |
| Heated | Wt % | At % | Wt % | At % | Wt % | At % | Wt % | At % |
| Au 5 nm, Ti 25 nm | 81.9 | 89.8 | 10.4 | 8.5 | 5.9 | 1.6 | 1.8 | 0.1 |
| Au 10 nm, Ti 20 nm | 73.2 | 81.2 | 21.5 | 17.9 | 2.4 | 0.7 | 2.8 | 0.2 |
| Au 25 nm, Ti 5 nm | 69.5 | 83.1 | 17.7 | 15.6 | 1.6 | 0.5 | 11.2 | 0.8 |
| Sample | C | O | Ti | Au | ||||
|---|---|---|---|---|---|---|---|---|
| Unheated | Wt % | At % | Wt % | At % | Wt % | At % | Wt % | At % |
| Au 5 nm, Ti 25 nm | 62.5 | 88.3 | 8.4 | 8.9 | 0.9 | 0.3 | 28.1 | 2.4 |
| Au 10 nm, Ti 20 nm | 77.3 | 91.4 | 8.3 | 7.3 | 1.2 | 0.4 | 13.3 | 0.9 |
| Au 25 nm, Ti 5 nm | 71.5 | 87.4 | 11.1 | 10.2 | 4.9 | 1.5 | 12.5 | 0.9 |
| Heated | Wt % | At % | Wt % | At % | Wt % | At % | Wt % | At % |
| Au 5 nm, Ti 25 nm | 69.0 | 83.9 | 16.2 | 14.8 | 0.6 | 0.2 | 14.2 | 1.0 |
| Au 10 nm, Ti 20 nm | 67.1 | 89.3 | 8.3 | 8.3 | 1.9 | 0.7 | 22.7 | 1.8 |
| Au 25 nm, Ti 5 nm | 79.5 | 89.8 | 10.3 | 8.7 | 3.5 | 1.0 | 6.7 | 0.5 |
| As-Sputtered Samples | Growth Reduction [%] | Heated Samples | Growth Reduction [%] |
|---|---|---|---|
| Pristine | 22.3 | - | - |
| Au 5 nm, Ti 25 nm | 85.0 | Au 5 nm, Ti 25 nm | 82.7 |
| Au 10 nm, Ti 20 nm | 75.1 | Au 10 nm, Ti 20 nm | 75.8 |
| Au 25 nm, Ti 5 nm | 69.3 | Au 25 nm, Ti 5 nm | 61.2 |
Publisher’s Note: MDPI stays neutral with regard to jurisdictional claims in published maps and institutional affiliations. |
© 2021 by the authors. Licensee MDPI, Basel, Switzerland. This article is an open access article distributed under the terms and conditions of the Creative Commons Attribution (CC BY) license (https://creativecommons.org/licenses/by/4.0/).
Share and Cite
Slepička, P.; Fajstavr, D.; Krejčová, M.; Rimpelová, S.; Slepičková Kasálková, N.; Kolská, Z.; Švorčík, V. Biopolymer Composites with Ti/Au Nanostructures and Their Antibacterial Properties. Pharmaceutics 2021, 13, 826. https://doi.org/10.3390/pharmaceutics13060826
Slepička P, Fajstavr D, Krejčová M, Rimpelová S, Slepičková Kasálková N, Kolská Z, Švorčík V. Biopolymer Composites with Ti/Au Nanostructures and Their Antibacterial Properties. Pharmaceutics. 2021; 13(6):826. https://doi.org/10.3390/pharmaceutics13060826
Chicago/Turabian StyleSlepička, Petr, Dominik Fajstavr, Markéta Krejčová, Silvie Rimpelová, Nikola Slepičková Kasálková, Zdeňka Kolská, and Václav Švorčík. 2021. "Biopolymer Composites with Ti/Au Nanostructures and Their Antibacterial Properties" Pharmaceutics 13, no. 6: 826. https://doi.org/10.3390/pharmaceutics13060826
APA StyleSlepička, P., Fajstavr, D., Krejčová, M., Rimpelová, S., Slepičková Kasálková, N., Kolská, Z., & Švorčík, V. (2021). Biopolymer Composites with Ti/Au Nanostructures and Their Antibacterial Properties. Pharmaceutics, 13(6), 826. https://doi.org/10.3390/pharmaceutics13060826

